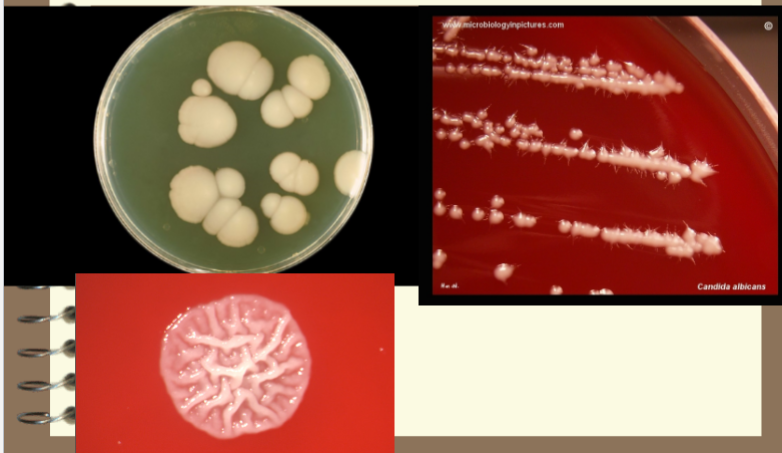

yeasts
1/54
There's no tags or description
Looks like no tags are added yet.
Name | Mastery | Learn | Test | Matching | Spaced |
|---|
No study sessions yet.
55 Terms
yeasts are important
– Beer and wine industry
– Bread industry
– Champagne
• Saccharomyces cerevisiae for ales and
Saccharomyces uvarum for lagers
general characteristics
Eukaryotic cells
4 Ubiquitous in nature
4 Approximately 1000 spp. of yeast
4 About 30 spp. known to Cause disease in
man
4 Reproduce by budding
4 When buds remain attached and elongate,
call
pseudohyphae
4 Significant part of the normal flora of
humans
occurrence
Skin and mucous membranes.
4 Most infections are endogenous
4 Infections start as localized lesions on
mucous membranes
4 then disseminates
4 True yeast are perfect fungi (both sexual
and asexual)
4 Yeast-like organism are imperfect fungi.
severity of disease depends on
Most yeasts are opportunist
4 Lack offensive properties
– They just wait for their chances
4 Yeasts are the most frequently isolated fungus
4 State of host defenses
4 How long condition exists.
4 Prolonged use of antibiotics
4 Immunosuppressive disease (AIDS)
4 Immunosuppressive drugs (Steroids, prednisone)
4 Cancer chemotherapy, radiotherapy
4 Increased use of invasive procedures
other predisposing factors
Diabetes mellitus
4 Malnutrition
4 Pregnancy
4 Oral contraceptives
4 Diets with lower the pH of the mouth and
vagina
4 Lymphoma and leukemia
4 Occupational
– hands are frequently immersed in water
specimen source
Found in virtually all kinds of specimens
4 Sputa and other respiratory
4 Skin and nail scrapings
4 Biopsy material
4 Mucocutaneous lesions
4 Corneal scrapings
4 Vaginal discharge
4 Urine: plate quantitatively
4 Blood: use 1:10 ratio
4 Bone and CSF
4
Remember, yeast are normal flora.
4
Which isolate is the contaminant or pathogen?
specimen handling
No special procedures necessary
4Rapid transport
4Do not give organisms time to multiple
4Multiplication gives erroneous picture
4Not be given time to change
morphology
culture and isolation
Sabouraud Dextrose:
4Sab. with Chloramphenicol and
cycloheximide
4IMA +chloramphenicol
4BHI + 5-10% blood:
4Caffeic acid agar –
Cryptococcus
caffeic acid agar/bird seed agar
Contains Niger bird seed extract
–
Guizotia abyssinica
–
Cryptococcus produces enzyme, phenol
oxidase
– Reduces the caffeic acid to melanin
– Develops brown pigment in the colony
4Presumptive for
Cryptococcus
neoformans
stains
Gram stain
4 10% KOH (skin, hair, and nails)
4 PAS
4 Methenamine silver
4 Mucicarmine
4 Calcofluro white
4 India Ink:
C. neoformans, encapsulated
direct examination
Skin or nail scrapings, clear with KOH
4Unicellular forms without
pseudohyphae or hyphae
– suggest colonization
4Presence of pseudohyphae or hyphaein fresh specimens, indicate infection
candida spp
Candida albicans
– The most frequently encountered fungal opportunist
– Serious fungal disease.
4 Other Candida Spp.
4
C. tropicalis
4
C. parapsilosis
4
C. glabrata
4
C. dubliniensis
4
C. krusei
4
C. kefyr
4
C. auris
disease spectrum of candida
Candidiasis, (Moniliasis)
4Mucocutaneous involvement
– Thrush, glossitis, stomatitis
– Vaginitis
– Bronchial pulmonary
– Alimentary, perianal disease
– Chronic mucocutaneous candidiasis
– Mycotic keratitis
cutaneous involvement
Paronychia
4Onychomycosis
4Diaper disease
4Candida Granuloma
4Otitis externa
systemic involvement
Urinary tract
4Endocarditis
4Meningitis
4Septicemia
4Iatrogenic cardioedema
4Allergic disease -eczema, asthma,
gastritis
candida albicans
Reservoir:
– Worldwide on fruits and vegetables
– endogenous inhabitant of
• alimentary canal
• mucocutaneous regions
• skin.
4 Special precautions: None
4 Culture media:
– BAP, Choc, inhibited by MAC, EMB
– SDA, modified SDA with cycloheximide
C. albicans macroscopic morphology
– White pasty, waxy, dry convex colonies
– Resemble staph
– Over time, colonies become tan and
rough
– Grows at 1-2 days @ 25-37o C
– Pseudohyphal fringes on periphery
– Develop true hyphae
Candida albicans SDA

C. albicans microscopic morphology
Microscopic Morphology:
– Pseudohyphae
– Blastoconidia
– Ovoid, thin walled Blastoconidia
• 6 - 10 um
• Occur in tight clusters
• at constrictures of pseudohyphae
– Pseudohyphae are elongated chains (linked
sausages).
– Terminal (thick walled) chlamydospores

C. albicans structures

more C. albicans blast conidia

lab id of Candida albicans
Positive Germ Tube Test:
– Incubate 2-4 hrs in fetal calf serum
– Observe for germ tube formation
– Filamentous outgrowth from blastoconidium
– Sides are approximately parallel,
– with no constrictions.
– > 90% of isolates positive for germ tube test
are
C. albicans.

Candida albicans germ tube

summary of lab features for Candida albicans
Yeast-like colonies
4 Blastoconidia and pseudohyphae
4 Germ tube
4 Terminal chlamydospores
4 Carbohydrate assimilation test (API yeast)
4 Negative for capsules
4 Resistance to cycloheximide
treatment for C. albicans
Nystatin
4Miconazole
4Fluconazole
4Ketoconazole
4Amphotericin B
Candida dubliniensis
Isolated from blood stream infections and
occasionally other sites
4 Cream colred, smooth,yeast like colonies
4 Microscopically similar to C. albicans
– Pseudohyphae and some true hyphae develop on
cornmeal agar
– Clusters of blastoconidia (C. albicans typically singular)
– Positive germ tube test
4 Negative for assimilation of xylose, alpha-methyl-
D-glucoside (MDG) and trehalose
*C. albicans positive

Candida tropicalis
Second only to
C. albicans
– as the cause of serious candidiasis
• immunocomprimised patients
4Pathogenicity
– Vaginitis,
– intestinal disease,
– bronchopulmonary and system infections
– meningitis, thrush, endocarditis and
fungemia
Forms yeast like colonies at both 25o and
37o C.
4 Ovoid or elongate blastoconidia
4 Abundant lone branching pseudohyphae.
4 True hyphae may also be formed.
4 Germ tube negative.
4 Capsule negative
4 Surface film with bubbles in SDB
candida tropicalis microscopic


Candida parapsilosis
Isolated in urinary tract infections,
4pyelonephritis
4endocarditis
4cutaneous
4paronychia
4otitis externa
4mycotic keratitis
4fungemia, and vaginitis.
Yeast like colonies at
both 25 and 37o C.
4 Blastoconidia and
pseudohyphae
4 Short, curved
pseudohyphae cells
– develop into giant cells
4 Germ tube negative
4 Chlamydospore
negative
4 Capsule neg
4 Sensitive to
cycloheximide

candida glabrata
Found worldwide.
4 Saprophyte of soil and dairy products
4 Endogenous flora:
– skin, oral cavity, GI tract and urogenital tract.
4 Opportunistic pathogen.
4 Fungemia is most common
4 Lung infections, endocarditis, meningitis,
UTI, and vaginitis.
4 Use media free of cycloheximide
candida glabrata on SDA or CMT
On SDA or CMT
agar
– moist, smooth, shiny
white colonies
– darken with age
– Optimal growth is
25o C.
– Grows in 3 days.

candida glabrata wet preps
In wet preps;
– unicellular, globose multilateral budding
yeast. (2-4.5 um).
– No pseudohyphae produced
– Capsule, germ tube, and Chlamydospore
negative.
– Sensitive to cycloheximide
– Urease, nitrate and carbohydrate
assimilation tests

candida species

lab tests for Candida species

candida auris
Candida auris is an emerging fungus that presents a
serious global health threat.
4 CDC is concerned about C. auris for three main reasons:
– It is often multidrug-resistant meaning that it is resistant to
multiple antifungal drugs commonly used to
treat Candida infections.
– It is difficult to identify with standard laboratory methods, and it
can be misidentified in labs without specific technology.
– It has caused outbreaks in healthcare settings.
4 Healthcare facilities or laboratories that suspect they
have a patient with C. auris infection should contact
state or local public health authorities and CDC
immediately for guidance.
candida auris identification
There have been reports of C. auris being misidentified as Candida
lusitaniae and Candida famata on VITEK 2. A confirmatory test such
as cornmeal agar may be warranted for these species.
4 C. guilliermondii, C. lusitaniae, and C. parapsilosis generally make
pseudohyphae on cornmeal agar.
4 If hyphae or pseudohyphae are not present on cornmeal agar, this
should raise suspicion for C. auris as C. auris typically does not make
hyphae or pseudohyphae.
4 An increase in infections due to unidentified Candida species in a
patient care unit, including increases in isolation of Candida from urine
specimens, should also prompt suspicion for C. auris, since C.
auris can be transmitted in healthcare settings.

C. auris microscopic

how to identify C. auris
Diagnostic devices based on matrix-assisted laser
desorption/ionization time-of-flight (MALDI-TOF) can
differentiate C. auris from other Candida species
– bioMérieux VITEK (MALDI-TOF) MS using the FDA-approved
v3.2
4 Molecular methods based on DNA sequencing can also
identify C. auris. Accepted methods include sequencing of
the D1-D2 region of the 28s ribosomal DNA (rDNA)
4 VITEK 2 with software version 8.01 should also be able to
accurately detect C. auris
candidiasis treatment
Cutaneous
– topical ketoconazole, miconazole
4System
– amphotericin B
– fluconazole
4Mucocutaneous
– amphotericnB
– Fluconazole
– Transfer factor
chronic mucocutaneous candidiasis
Chronic mucocutaneous candidiasis
(CMC) is the label given to a group of
overlapping syndromes that have in
common a clinical pattern of persistent,
severe, and diffuse cutaneous candidal
infections. These infections affect the
skin, nails and mucous membranes.
Immunologic studies of patients with
CMC often reveal defects related to
cell-mediated immunity, but the defects
themselves vary widely
mucutaneous candidiasis: response to fluconazole
Transfusion of a Candida-specific
transfer factor has been reported to be
very successful (remission for > 10
years) when combined with antifungal
therapy.
The availability of effective oral agents,
especially the azole antimicotics, has
dramatically changed the life of
patients living with CMC.
cryptococcus neoformans
Found worldwide
4 Wherever pigeons roost
4 Chief vector is the pigeon
4 Yeast is able to survive passage through
pigeon gut
4 Remains viable for 2 years or longer in
excreta around nesting area
cryptococcus pathogenicity
Small virulent organisms found in dust
4 Acquired via inhalation.
4 They enter the alveolar spaces in lung
4 Produce capsule, cause disease
4 Can move systemic
4 Other species have similar pathology
–
Cryptococcus gattii
cryptococcus neoformans isolation
Isolated from dairy products, fruits and
pigeons droppings
4
C. neoformans is considered an opportunist.
4 Underlying immunodeficiency, AIDS.
4 Chronic or subacute pulmonary infection.
4 Has a predilection for the CNS.
4 Meningitis is the common form of
Cryptococcosis.
cryptococcus neoformans colony morphology
– SDA: tiny, dome shaped
– White to tan colonies in 2-4 days.
– They may be yellow to light pink or light brown.
– If organism has a capsule, colonies will be
mucoid
– Niger Bird Seed Agar
• Brown colonies
• Production of phenol oxidase enzyme
• Exclusive property of
Cryptoccus neoformans

cryptococcus neoformans plate

cryptococcus neoformans microscopic morphology
– thin walled, globose or oval shaped yeast.
– Varies greatly in size.
– Occurs singularly or in pairs
– No pseudohyphae or true hyphae.
– Budding may be single or double
• narrow points of attachment.
• Narrow base buds
– Refractile mucopolysaccharide capsule

cryptococcus in spinal fluid

helpful lab features cryptococcus neoformans
– Yeast like colonies at 25 and 37o C.
– Slimy yeast like colonies.
– Large single or budding yeast.
– Absence of pseudohyphae.
– Capsule positive
– Germ tube negative
– Chlamydospore negative
– Sensitive to cycloheximide
– brown colonies on caffeic acid agar.
• Bird seed agar
• Phenol oxidase enzyme
cryptococcus - caffeic acid agar

helpful lab tests for cryptococcus
– India Ink stain to demonstrate capsule.
– Crytococcal antigen test (more sensitive
than India ink).
– Latex agglutination test for
polysaccarrhide capsular antigens.
– Can be grouped into four serotypes: A,
B, C, D. (A = 95% of U.S. cases)
india ink stain

cryptococosis treatment
Amphotericin B
4+ Flucytosine
4life long fluconazole prophylaxis in
AIDS patients
rhodotorula
Rare fungemia in
immunocompromised
patients
4 Macroscopic morphology:
Pink to coral colored
colonies with wet, soft
appearance
4 Microscopic morphology:
Budding cells are round to
oval, occasional rudimentary
pseudohyphae

pneumocystis spp
Originally thought to be a protozoan
4 Nonfilmanetous fungus
4 Pneumonia -immunocompromised patients
– Non-productive cough, fever, difficulty breathing
4 Live stages still referred to by protozoan names; trophozoite, precyst
and cyst
– Cyst is the infective stage via respiratory transmission
4 P. carinii and P. jirovecii most prevalent species
4 Specimen Source: Bronchoalveolar Lavage Fluid or Bronchial
Washings or Induced Sputum
4 Specimen is prepared, cytospun and fixed onto a slide for staining with
silver stain or alternate
